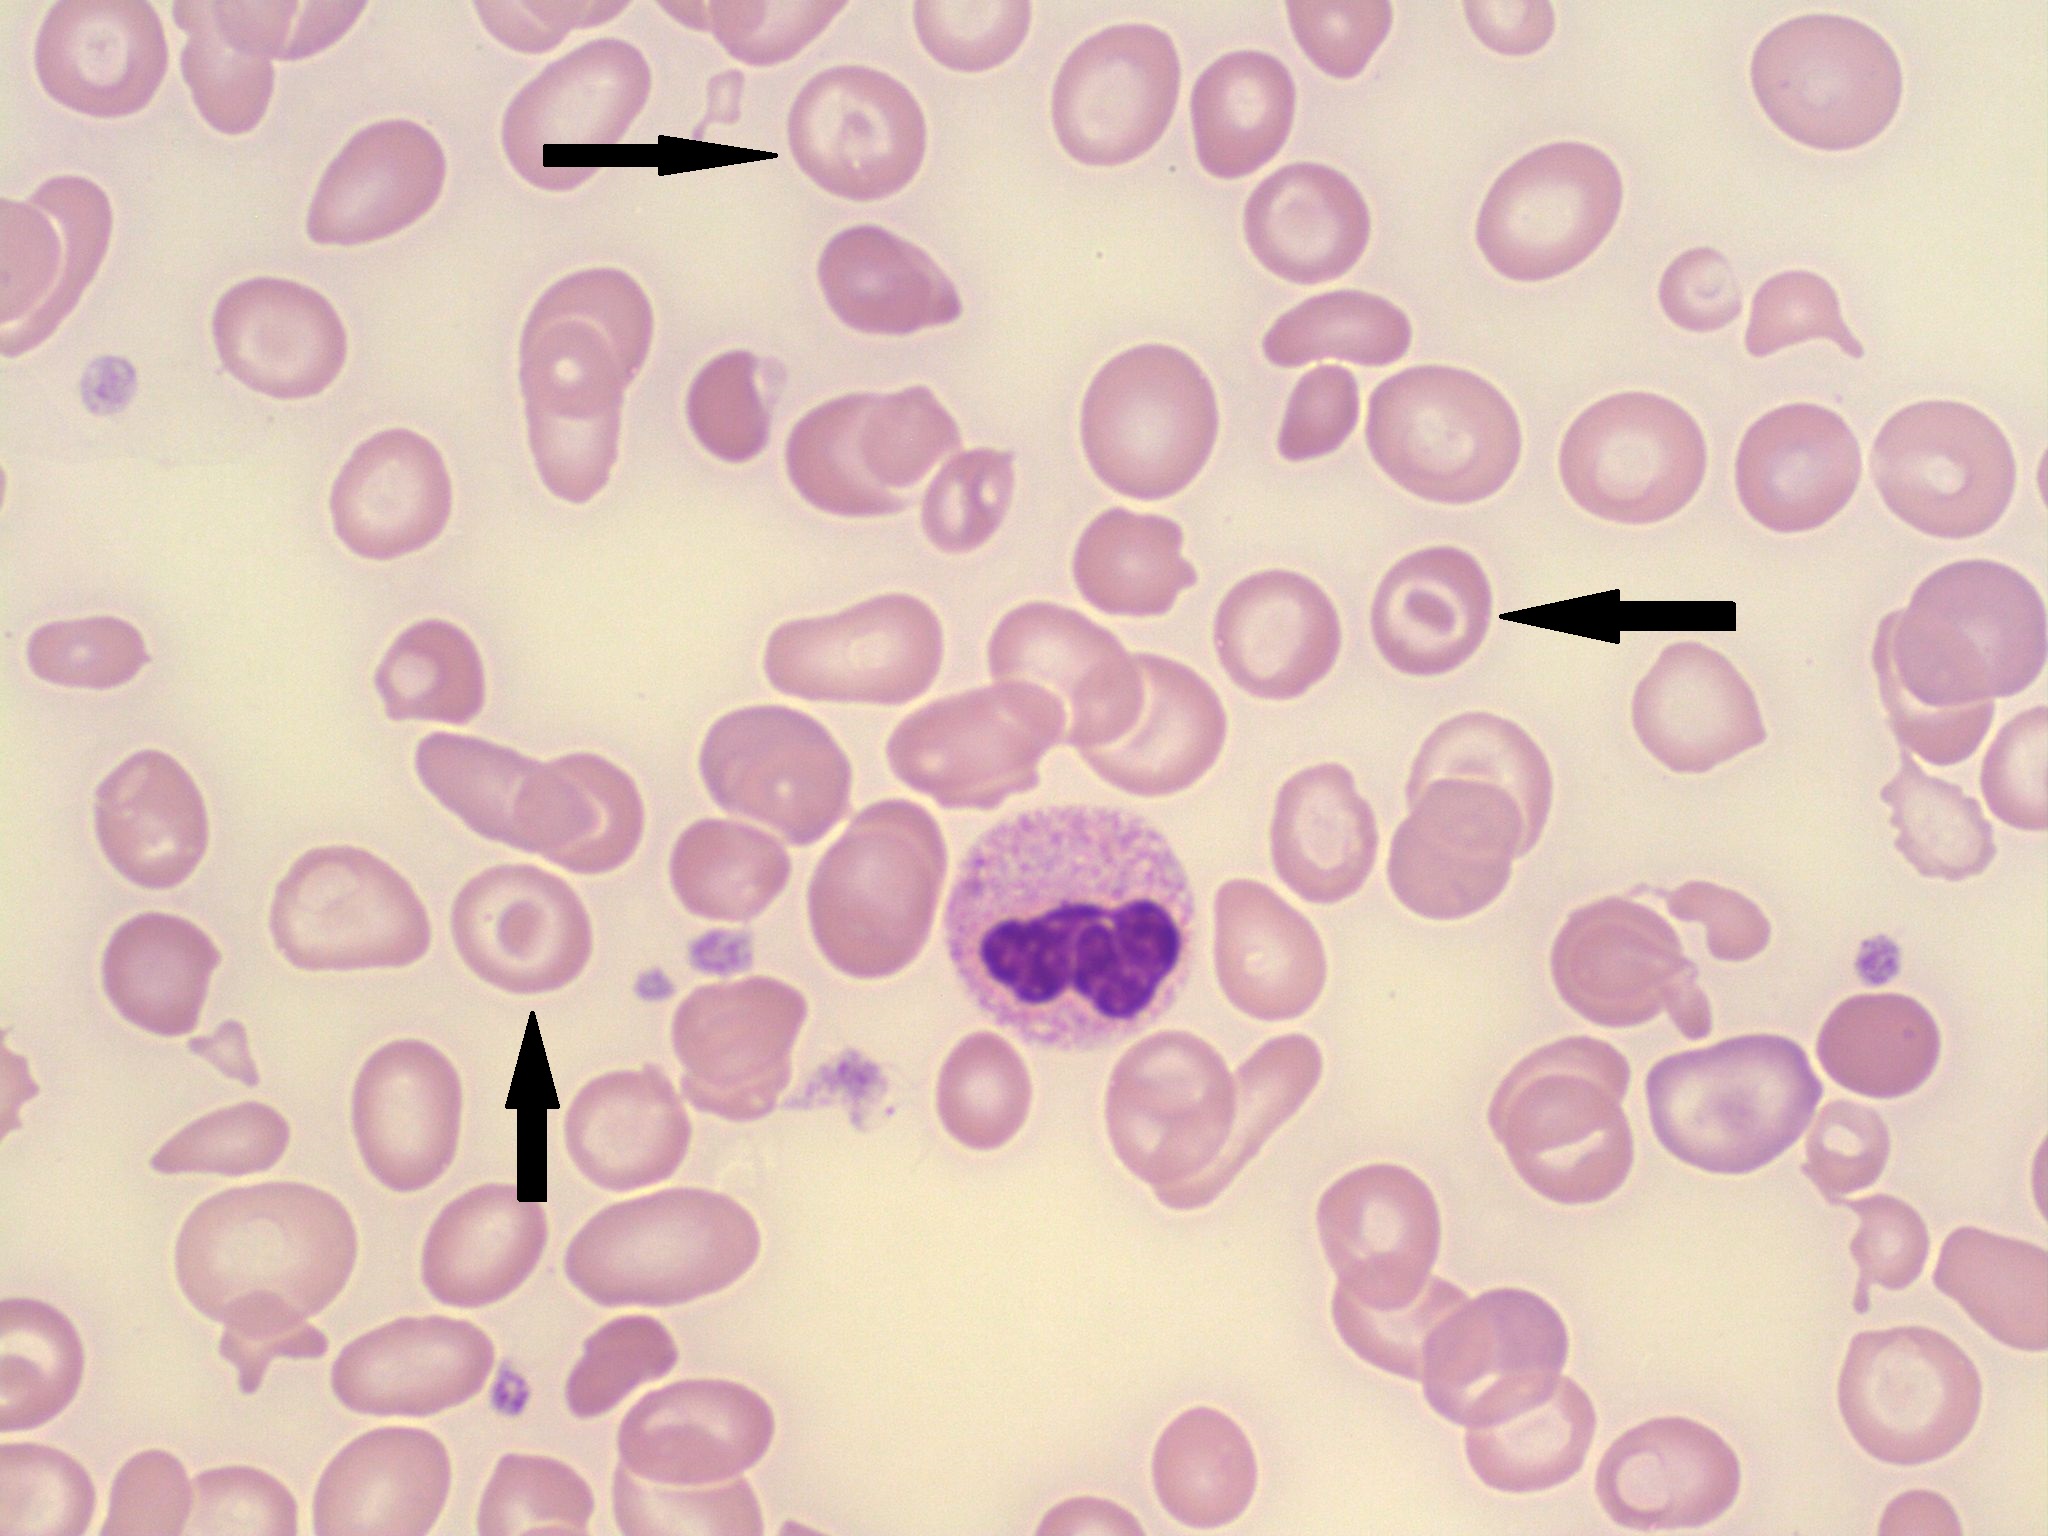
term image
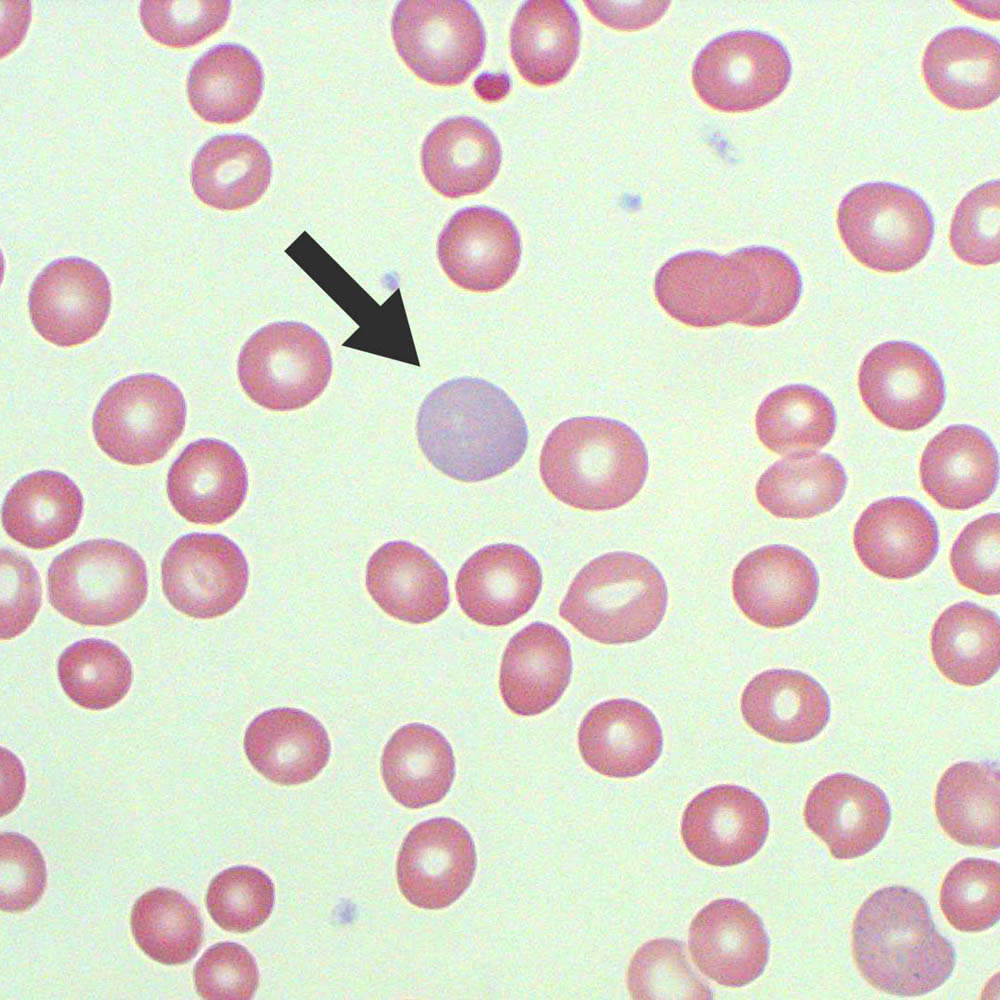
term image

1/58
Looks like no tags are added yet.
Name | Mastery | Learn | Test | Matching | Spaced | Call with Kai |
|---|
No analytics yet
Send a link to your students to track their progress
Red Blood Cells
erythrocytes
White Blood Cells
leukocytes
Platelets
thrombocytes
RBC function
oxygen transport
WBC function
body defense
Mononuclear cells
monocytes and lymphocytes
Granulocytes
neutrophils, eosinophils, basophils
Platelet function
blood clotting
Neutrophils appearance
segmented or banded nuclei (2-5 lobes), granular cytoplasm
Neutrophils function
phagocytosis
Most abundant WBC
neutrophil
Eosinophil appearance
segmented nuclei (2+), red/orange granular cytoplasm
Eosinophil function
kill parasitic worms; complex role in allergy and asthma
Basophil appearance
cytoplasmic granules cover entire cell
Least common WBC
basophil
Basophil function
mediates inflammation; release histamine
Lymphocyte appearance
Large nucleus with clear blue cytoplasm.
Lymphocyte function
immune response
Monocyte appearance
largest cell, large nucleus, can have holes
Monocyte function
phagocytosis
Platelet appearance
no nucleus, small, stain blue/purple
Erythrocyte appearance
pink/red, no nucleus, round shape
Polychromasia
Immature RBC, multi colored
Target cell
associated with sickle cell, looks like a target
Sickle cell
shriveld up RBC
Schistocytes
RBC fragments
tear drop RBCs
All in one direction indicates poor smear
Nucleated RBC
immature RBC; seen in infants, and rapid blood loss
Blood smear prep
1 drop of EDTA blood, smear using two slides, label slide
Good blood smear
feathered edge, spans 2/3 of slide length, covers whole width, no scrapes/bubbles
What stain is used for blood smears
Wright-Giemsa
Wright (Methylene blue + eosin) function
fixes stain
Giemsa
stains everything blue
Why is a buffer used in the staining process?
to neutralize the pH
What is the last step of the staining process (stain, buffer, then…)
H2O rinse
Blood smear scan
use 100x and oil, start count at area with monolayer cells, navigate and count WBC until 100 cells are counted
Neutrophil normal value
54-62%
Lymphocyte normal value
25-33%
Monocyte normal value
3-9%
Eosinophil normal value
1-3%
Basophil normal value
<1%
Elevated neutrophils
bacterial infections, stress
Elevated lymphocytes
Mono, whooping cough, viral infections
Elevated monocytes
malaria, TB, fungal infections
Elevated eosinophils
parasitic worms, allergic reactions
Elevated basophils
cancer, chicken pox, autoimmune disorders

neutrophil

eosinophil

basophil

erythrocyte

monocytes

lymphocytes

platelets
target cells
polychromasia

nucleated RBC

sickle cell

schistocytes

teardrop cells